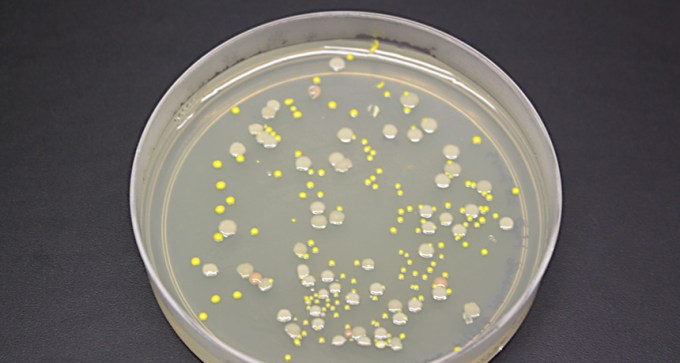
Active bacterial communities

Evolve and Linkage turn science into games
In the two new games Evolve and Linkage, biological principles are made entertaining and strategic.
Every print subscription comes with full digital access

West Africa’s Ebola epidemic captured the attention of both the scientific world, and the world at large in 2014, placing it first among the Top 25 stories of the year.

In the two new games Evolve and Linkage, biological principles are made entertaining and strategic.

A photo archive from the U.S. Geological Survey's Bee Inventory and Monitoring Lab offers detailed photos of bee species.

In remote India, a rare frog mates and lays eggs inside bamboo stalks. The eggs hatch into froglets, forgoing the tadpole stage.

Scientists and journalists share a core belief in questioning, observing and verifying to reach the truth. Science News reports on crucial research and discovery across science disciplines. We need your financial support to make it happen – every contribution makes a difference.

West Africa’s 2014 Ebola epidemic showed what can happen when a contagious virus emerges where cultural practices, public fears and porous borders fuel the spread of disease.

A possible signal from moments after the Big Bang may be due to dust in the Milky Way galaxy.

DNA of the oldest modern humans is rewriting the prehistories of Europe, Siberia and the Americas.

Simple-looking structures create sophisticated one-way air flow in iguana lungs, undermining old scenarios of lung evolution.

Powerful plasma jets from cores of galaxies seem to mysteriously align with one another and hint at an unknown mechanism shaping galaxy groups.

Repulsive matter could have played a role in the early universe, a computational study finds.

New measurements by robotic subs suggest that scientists have underestimated Antarctic sea ice thickness.

Polymer solar cells capture more sunlight when they are imprinted with movies’ and TV shows’ Blu-ray Disc etchings.

Vultures’ guts are chock-full of bacteria that sicken other creatures.

A new class of drugs uncloaks tumors in some patients, awakening home-grown cells to fight several cancer types.

Wiring replacement organs into the body may be as easy as discharging a biological battery, new experiments with tadpoles suggest.

The Rosetta spacecraft and its lander Philae are providing an intimate look at the life of comet 67P/Churyumov-Gerasimenko.

New experimental results in 2014 helped bring scientists closer to understanding how the brain manipulates memories to make sense of the world.

Indonesian Homo erectus carved zigzags on a shell at least 430,000 years ago.

New results from the Planck satellite provide the most detailed look yet of the makeup of the universe.

Light from newborn stars drives gas out of a distant galaxy, a process that may prevent future stars from being born.

The antidepressant tranylcypromine might also work as antiviral against herpes, animal studies suggest.

Greenhouse gases played a role in boosting rainfall in Africa 14,000 to 21,000 years ago, a finding that may help predict future abundance of water on the continent.

Triclosan, an unregulated antimicrobial chemical found in consumer products, may aid, rather than deter, microbes that invade people’s bodies.

Humans can suss out more than 1 trillion different smells, a 2014 study estimated.

An incredibly easy method for making stem cells turned out to be impossible, again tainting the stem cell research field with controversy.

Insects got an entirely new family tree after an extensive genetic analysis rearranged the creatures' relations.

A look at the genes of domesticated animals offers possible insights into why taming has altered animals’ appearances.

Stone Age cave painting began at about the same time in Southeast Asia as in Europe, challenging the idea that Western Europeans cornered the market on creativity 40,000 years ago.
Thousands of microbe species thrive in Lake Whillans deep beneath the West Antarctic ice sheet.

Jupiter’s frozen moon Europa has a shifting exterior analogous to Earth’s plate tectonics.

Saccharin messes with the body’s ability to metabolize fuel, a condition that often precedes diabetes, obesity and other metabolic problems.

Ingredients in young blood can rejuvenate old mice’s bodies and brains, scientists reported in 2014.

Electronic cigarettes dispense water vapor laced with flavors and often a hefty dose of nicotine. These vapors may be far from benign, studies in 2014 suggested.

This year, Kepler engineers figured out how to stabilize the almost-defunct Kepler telescope, while astronomers found hundreds more worlds.

With the discovery of several new species and a few dogma-shaking revelations, dinosaurs got a total rethink in 2014.

The IceCube experiment has started to pinpoint the birthplaces of some high-energy neutrinos.

NASA’s Cassini spacecraft builds a stronger case for a subsurface ocean on Enceladus that drives ice geysers on the moon’s south pole.

Birds' troubles received an eerie emphasis in the news when biologists marked the 100th anniversary of the death of the last known passenger pigeon.

Mars now has seven robots studying it and together they have given scientists their best view of any planet in the solar system other than Earth.

The genes and bones of the Clovis people reveal the range and legacy of the early North Americans.

Climate change is here and the world is unprepared, scientists and policy makers declared multiple times in 2014.

New genetic letters in bacteria and a simplified yeast chromosome showcase scientists' advances in understanding the simplicity and complexity of life.

In nighttime flying duels, Mexican free-tailed bats make short, wavering sirenlike sounds that jam each other’s sonar.

In 1964, researchers hoped to improve lung cancer diagnosis by measuring the skin’s electrical resistance.

In the race for Top Science Story of 2014, some of the contenders stumbled before reaching the finish line.

This year, scientists pegged microbes as important players in several aspects of human health, including obesity and cancer.

From the tiny Antarctic midge to the towering loblolly pine, scientists this year cracked open a variety of genetic instruction manuals to learn about some of Earth’s most diverse inhabitants.
Subscribers, enter your e-mail address to access the digital replica edition.